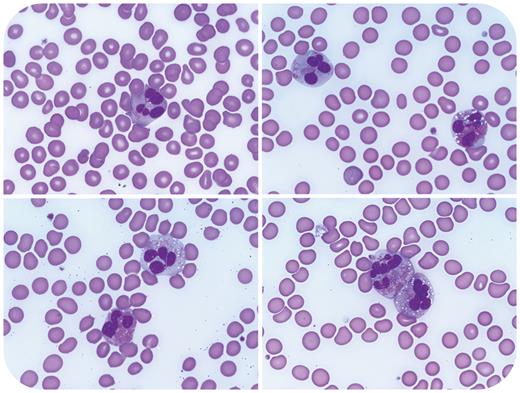
graphic

A 68-year-old man with a history of prostatic adenocarcinoma, status post–prostatectomy and radiation, presented with chest pain, exertional dyspnea, and syncope. Complete blood count showed absolute eosinophilia (3.5 × 109/L), anemia (hemoglobin 10.9 g/dL), and thrombocytopenia (97 × 109/L). A peripheral smear showed increased eosinophils with cytomegaly, abnormal granulation, cytoplasmic vacuolation, and atypical nuclear segmentation (shown above at 100× objective). Fluorescence in situ hybridization (FISH) performed on blood leukocytes detected loss of 1 copy of LNX1 (adjacent to CHIC2) in 15% of cells, resulting in FIP1L1::PDGFRA fusion. Fusions involving PDGFRB and FGFR1 were absent. BCR::ABL1 fusion and mutations in JAK2, CALR, MPL, KIT, and CSF3R were not identified. A bone marrow biopsy showed myelofibrosis but was compromised by crush artifact. A diagnosis of myeloid/lymphoid neoplasm with PDGFRA rearrangement was rendered. The patient’s blood counts and symptoms rapidly improved with imatinib and prednisone.
Generally, the distinction between reactive and neoplastic causes for eosinophilia cannot be reliably made based on the presence or absence of eosinophil atypia alone. Clinical exclusion of the many reactive etiologies for eosinophilia is pivotal, and in situations where a neoplasm is suspected, a multifaceted approach that includes FISH and next-generation sequencing analysis is often required. Detection of myeloid/lymphoid neoplasms with eosinophilia and tyrosine kinase gene fusions is paramount, as these neoplasms are highly responsive to treatment with imatinib.
For additional images, visit the ASH Image Bank, a reference and teaching tool that is continually updated with new atlas and case study images. For more information, visit https://imagebank.hematology.org.
This feature is available to Subscribers Only
Sign In or Create an Account Close Modal